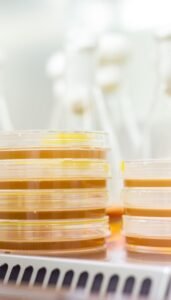

No products in the cart.

自設養殖基地和加工工廠
牛鼎天經營團隊於 2010 年起陸續於台灣各地區建設牛樟芝養殖基地,約 3000 平方米產區所生產實體原料已到達市場供需產值量。並在 2015 年於上海及廣東地區成立營運據點,2017 年在台灣成立牛鼎天生物技股份有限公司專注於牛樟物料萃取技術研發及產品製造。座落於桃園市中壢區之廠區具農技培植及食品生技加工製造廠規範設立建構而成,是國內少數能夠垂直整合牛樟芝復育/機能研發試驗、製造及保健品銷售規劃等核心能力的生技廠。

嚴格品質控制
除了以品質、技術及專業等提升集團競爭力外,積極建立台灣瑰寶「牛樟芝」品牌形象,攜手帶給全球人們更多養生保健新生活體驗,成為國際生技產業標竿。秉持著「品質J、「專業」與「安全」的堅持,從原料到最終的成品皆具備完整生產履歷及經過嚴格品質檢驗與質量檢驗報告。期許牛鼎天生物科技股份有限公司在牛樟芝的產業領域:以良好的服務品質及專業的能力打造消費者心裡最好的企業形象及品牌。

超臨界 CO2 流體萃取設備
本公司透過超臨界 CO2 流體萃取設備用於保健食品研發,透過核心研發技術萃取篩選更優質且高功效之成分,以作為未來植物新樂開發。本廠研發與牛產設備有:活性成分分析檢驗實驗設備、藥用菇菌栽培設備、室內菇蕈環控養殖設備、超臨界流體萃取設備、生產品管研發中心。透過專業研發團隊並同時掌握藥用菇菌類及中草藥之功效研究趨勢,逐漸針對保健食品研發、植物新藥研發等新興生物科技產業市場,作為全球化市場佈局之拓展基石。